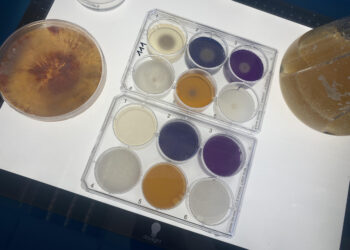
Produire des biocarburants de 2ème génération avec des champignons

Produire des biocarburants de 2ème génération avec des champignons
Les prouesse insoupçonnées des champignons: quatrième volet de notre série. Ce soir, des champignons capables d'aider à produire des biocarburants. Ou comment les champignons peuvent nous aider à nous déplacer ...